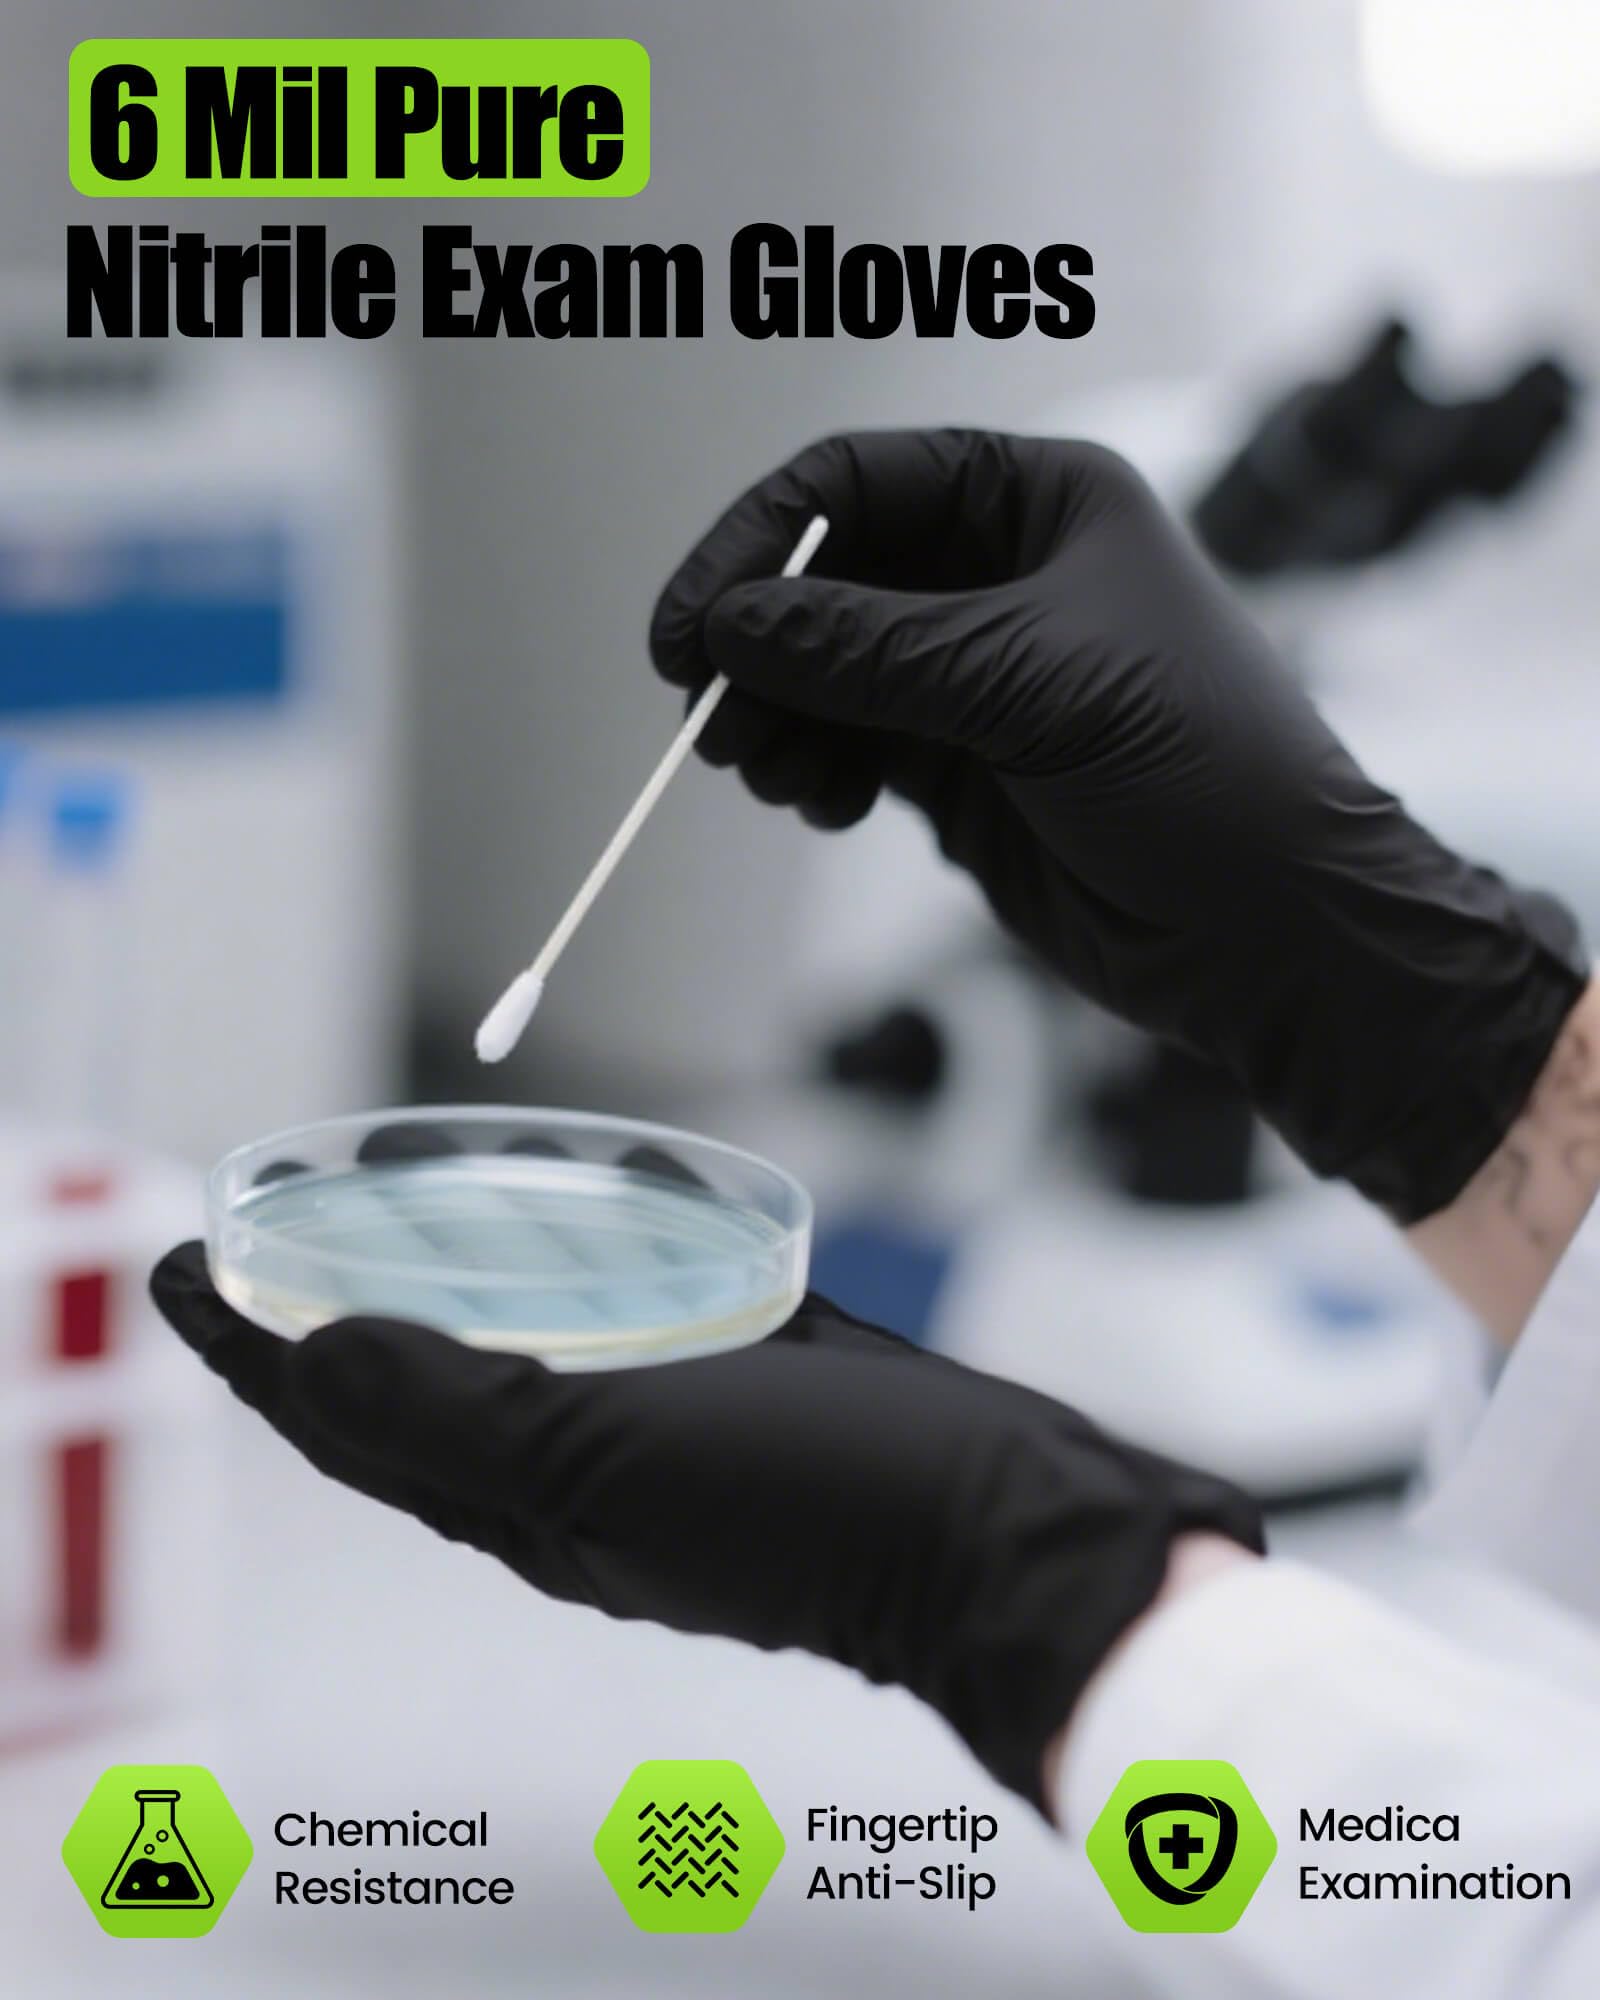

1
/
of
9
TREEGO
TREEGO 6 Mil Black Nitrile Gloves Large – Heavy Duty Disposable Latex & Powder Free, Chemical Resistant, Textured Grip for Industrial, Mechanic, Food Handling – 100 Count
TREEGO 6 Mil Black Nitrile Gloves Large – Heavy Duty Disposable Latex & Powder Free, Chemical Resistant, Textured Grip for Industrial, Mechanic, Food Handling – 100 Count
Regular price
$25.95 USD
Regular price
$51.99 USD
Sale price
$25.95 USD
Unit price
/
per
Tax included.
Shipping calculated at checkout.
Couldn't load pickup availability
Brand: TREEGO
Color: Black
Features:
- ▲ HEAVY-DUTY 6 MIL STRENGTH – Ideal for large hands, TREEGO 6 mil black nitrile gloves deliver the ultimate chemical and puncture resistance for tasks like construction, mechanical work, and food handling. These gloves offer superior protection against oil, solvents, and harsh chemicals in industrial settings.
- LATEX-FREE & POWDER-FREE – Made from high-quality latex-free nitrile, these gloves are safe for users with latex allergies, ensuring a comfortable and clean experience free from irritating powders.
- ▲ ENHANCED TEXTURED GRIP – Micro-textured fingertips improve grip and precision when handling wet tools, oily parts, kitchen utensils, or delicate instruments, ensuring safety and performance in both professional and household environments
- MULTIPURPOSE APPLICATIONS – Perfect for mechanics, construction workers, plumbers, and industrial cleaning professionals, these gloves provide reliable protection in a variety of environments.
- ALL-DAY COMFORT FIT – These gloves are designed to provide a snug fit for large hands, offering maximum flexibility and comfort for extended use without sacrificing performance or safety.
Binding: Apparel
model number: 6MBK-100L-YL2507
Part Number: 6MBK-100L
Package Dimensions: 9.0 x 4.9 x 2.7 inches
Share